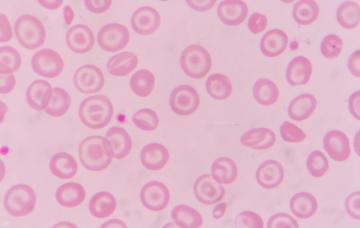

Talasemia

Especialista en Medicina Interna del Hospital Universitario Príncipe de Asturias
- 1

Qué es la talasemia
La talasemia es una anemia, y se caracteriza por una pérdida de glóbulos rojos, las células que transportan oxígeno a los tejidos y órganos del cuerpo.
Leer más - 2

Tipos de talasemias
Te explicamos las características más importantes de los dos tipos de talasemia más frecuentes: las alfa-talasemias y las beta-talasemias.
Leer más - 3

Síntomas de la talasemia
Los síntomas de talasemia son muy variables en función de su gravedad. El paciente puede sentir cansancio o tener dificultad para respirar, entre otros.
Leer más - 4

Diagnóstico de la talasemia
El diagnóstico de talasemia se basa en los resultados del análisis de sangre y de la electroforesis, aunque también se pueden realizar estudios genéticos.
Leer más - 5

Tratamiento de la talasemia
Cuando la talasemia precisa tratamiento, hay que realizar transfusiones de sangre, transplante de médula ósea, y otros procedimientos que te contamos.
Leer más